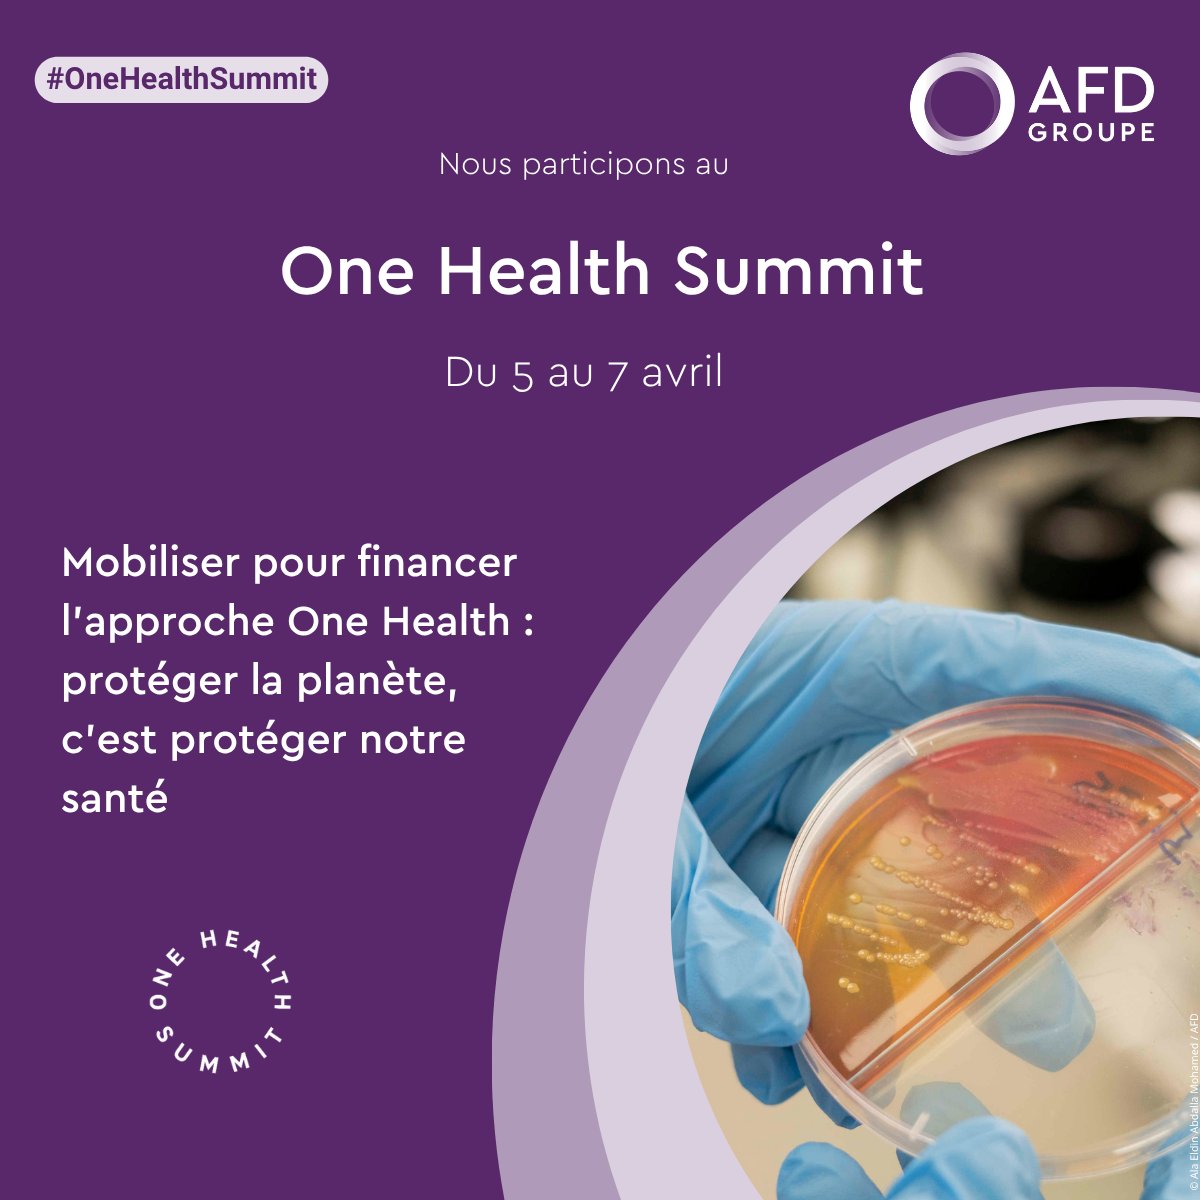
AFD_en 🇫🇷 🇪🇺 tweet media

#OneHealthSummit
🦟 75% of emerging infectious diseases come from animals. The #OneHealth approach (human, animal & environmental health combined) is central to our work.
🤝 @institutpasteur @WHO @expertisefrance @oneplanetsummit @Cirad @AVSF_ONG @sup_recherche @ird_fr
English